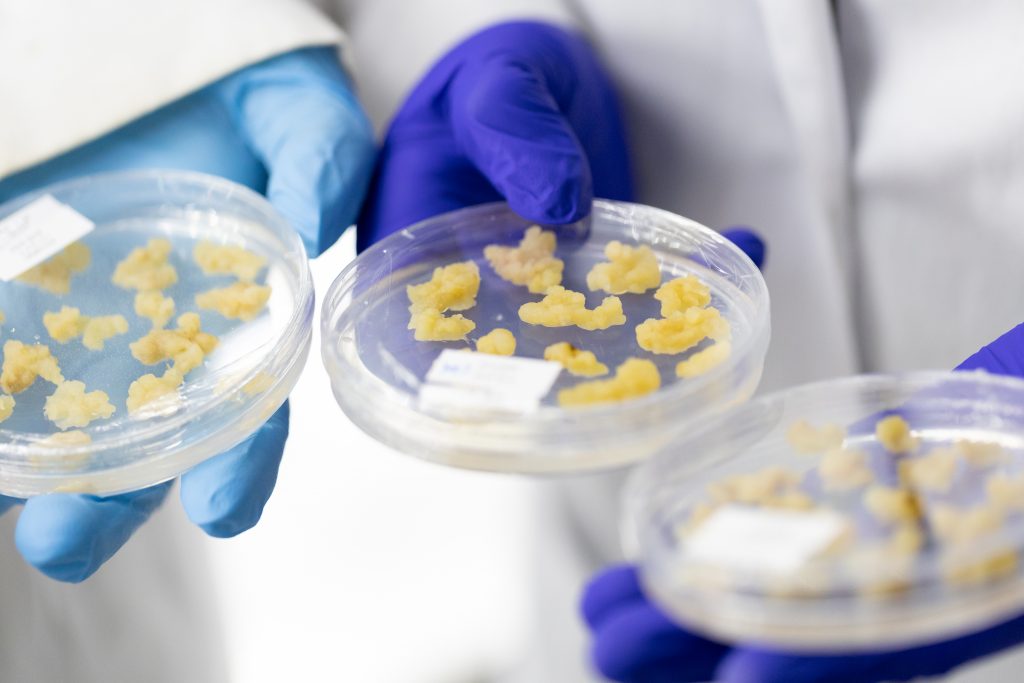
Laboratorios UdeC

CICUA-UdeC fortalece su compromiso ético y operativo tras primer año de gestión
El Comité Institucional de Cuidado y Uso de Animales de la Universidad de Concepción presentó avances de su trabajo centrado en el bienestar animal, la bioseguridad y el desarrollo del Programa Institucional de Cuidado y Uso de Animales.